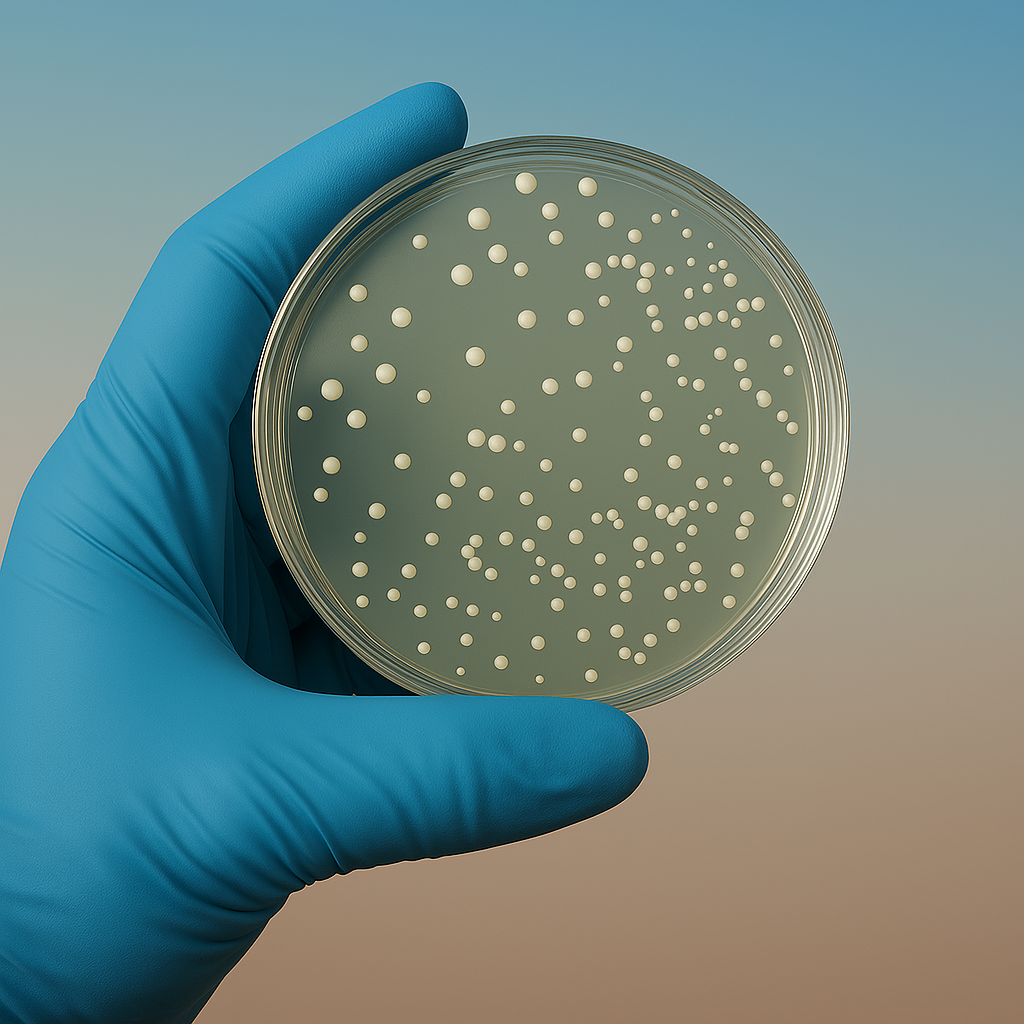

Avec le On-Farm™,
améliorez votre rentabilité
en produisant
vos bio-intrants
Une ferme française contrainte à l'évolution
Les pressions à la fois économiques, sociales et réglementaires nous obligent à repenser les modèles existants pour pouvoir transmettre à la prochaine génération des exploitations pérennes sur les plans économiques comme agronomiques.
Les intrants sont au cœur de vos enjeux
Les nouvelles générations d'intrants, les bio-intrants, offrent des opportunités pour adresser vos enjeux de volatilité des charges, de diversification des revenus et d'anticipation des évolutions réglementaires. Chez BioFerm'Tech, nous souhaitons rendre ces opportunités concrètes à travers la structuration de la première filière On-Farm™ en Europe et nous bénéficions pour cela du soutien de plusieurs acteurs nationaux et régionaux d'envergure.
Vos bio-intrants produits chez vous
Le On-Farm™ c’est un modèle de production décentralisé de bio-intrants agricoles destinés à l'autoconsommation comme à la vente.
01
Nous vous fournissons la bactérie et son milieu de culture. Nous repartons de matières premières fraîches à chaque nouvelle multiplication pour garantir son efficacité.
02
Nous produisons vos bio-intrants chez vous. Notre technicien prend en charge la multiplication des micro-organismes de A à Z sur le module mis à disposition chez vous. Pas de temps à passer pour vous !
03
Nous assurons le contrôle qualité. En fin de cycle, nous prélevons un échantillon pour pouvoir tester et libérer le lot. Le but : vous permettre d'autoconsommer ou de vendre votre production en étant serein sur son efficacité et sa conformité.
04
Et hop, dans le pulvé. Une fois multipliées, les bactéries peuvent être stockées pendant plusieurs semaines à plusieurs mois puis utilisées dans les champs avec votre matériel de pulvérisation habituel.
Réduire par deux le coût des bio-intrants
L'intérêt premier du On-Farm™ est que ce mode de production permet de réduire drastiquement le coût de revient des bio-intrants. En effet, il élimine les principaux défis techniques rencontrés dans les modes de production existants. Cela tient à deux raisons :
Les micro-organismes constituent une matière active vivante. Aujourd'hui, les industriels les distribuent et les stockent comme s'ils étaient des molécules inertes stables comme les intrants de synthèse, mais cela ne va pas de soi ; c'est même un véritable casse-tête.
En effet, pour cela il faut formuler les micro-organismes. En plus d'être multipliés comme pour le On-Farm™, les micro-organismes vont ainsi subir plusieurs étapes de transformation pour être stabilisés. Problème : cela représente jusqu'à 70% du coût de revient et devient le focus principal du développement produit, au détriment de l'agronomie.
Notre parti pris, c'est que l'émergence de nouvelles familles de produits appelle à développer de nouveaux modes d'organisation et de production. Et c'est ce qu'on compte bien démontrer avec vous avec le On-Farm™.
La beauté des micro-organismes ? L'étape de multiplication nécessite le même équipement de fermentation peu importe la souche (en absence de formulation !).
Versatile par nature, votre équipement On-Farm™ vous permettra donc à terme de produire une multitude de bactéries différentes. Elles seront autant d'outils agronomiques différents.
Plus vous utiliserez d'intrants microbiens, mieux vous amortirez l'équipement On-Farm™ et plus vous réduirez le coût de vos intrants !
Améliorez votre rentabilité avec les Biotechs
Les biotechnologies sont en train de révolutionner toutes les industries et l'agriculture ne fait pas exception. Ces technologies offrent aussi l'opportunité de remodeler les chaînes de valeur, en plus d'apporter de nouvelles solutions techniques comme les bio-intrants. Notre ambition chez BioFerm'Tech avec le On-Farm™, c'est de mettre les biotechnologies au service des agriculteurs pour leur permettre de regagner des marges de manœuvre à plusieurs niveaux :
Réduisez le coût de vos intrants
grâce à une production locale, circulaire et souveraine
Diversifiez vos activités et vos revenus
en participant à la création d'une nouvelle filière et du premier réseau On-Farm™ en Europe
Anticipez les évolutions réglementaires
en intégrant dans vos itinéraires techniques des intrants que vous maîtrisez et à la substance active durable
Votre projet autant que le nôtre
Nous tenons à faire du On-Farm™ un modèle pensé par et pour les agriculteurs. Notre ambition est de développer cette nouvelle filière en maillant le territoire avec des modules On-Farm™ portés par des groupes d'agriculteurs qui souhaitent innover et diversifier leurs activités. Notre solution est en cours de développement, c'est donc le moment de nous donner votre avis. Si l'aventure vous intéresse, n'hésitez pas, cliquez ci-dessous !
Votre projet autant que le nôtre
Nous tenons à faire du On-Farm™ un modèle pensé par et pour les agriculteurs. Notre ambition est de développer cette nouvelle filière en maillant le territoire avec des modules On-Farm™ portés par des groupes d'agriculteurs qui souhaitent innover et diversifier leurs activités. Notre solution est en cours de développement, c'est donc le moment de nous donner votre avis. Si l'aventure vous intéresse, n'hésitez pas, cliquez ci-dessous !